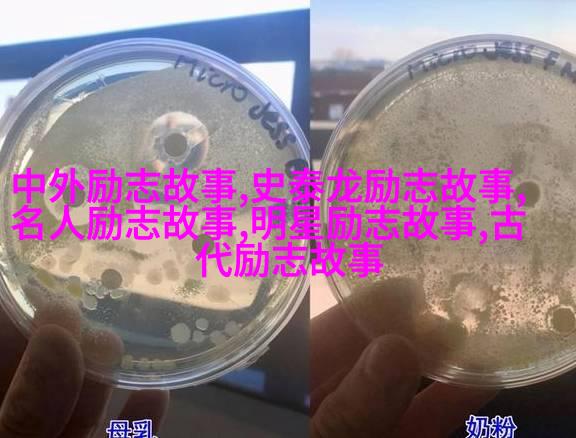

您现在的位置是: 首页 - 励志故事 - 努力奋斗不懈追求成功的坚定决心 励志故事
努力奋斗不懈追求成功的坚定决心
2025-04-24 【励志故事】 0人已围观
简介为什么要努力? 在这个竞争激烈的世界里,想要实现自己的梦想和目标,没有不断地努力是不够的。每个人都有自己的生活道路,每个人的成长过程都是充满挑战和困难的。但是,不管遇到多少挫折,我们都应该保持积极向上的态度,始终相信自己可以克服一切困难。 如何开始努力? 真正意义上的努力,从不仅仅是单纯地付出时间和精力,而是一种状态,一种心态。首先,要明确自己的目标是什么,这样才能知道自己需要为何而努力。然后
为什么要努力?

在这个竞争激烈的世界里,想要实现自己的梦想和目标,没有不断地努力是不够的。每个人都有自己的生活道路,每个人的成长过程都是充满挑战和困难的。但是,不管遇到多少挫折,我们都应该保持积极向上的态度,始终相信自己可以克服一切困难。
如何开始努力?

真正意义上的努力,从不仅仅是单纯地付出时间和精力,而是一种状态,一种心态。首先,要明确自己的目标是什么,这样才能知道自己需要为何而努力。然后,要制定合理有效的计划,把大目标分解成小步骤,每一步都有明确的方向和方法。这就是我们常说的“设定清晰可行”的原则。
面对困难时如何继续努力?

人生中总会遇到各种各样的挑战,有时候这些挑战会让我们感到无比疲惫,让我们想要放弃。但是,如果我们能够认识到每一次失败都是成长的一部分,那么即使再艰苦,也能坚持下来。重要的是要学会从失败中吸取经验教训,用它们来指导我们的下一步行动。
怎样保持持续性?

持续性的关键在于习惯。当一个行为变成了你的第二自然之举,你就不会感觉到了那么大的压力或痛苦。而且,当你看到结果的时候,你会更加动力十足,因为你知道你的所有辛勤工作并没有白费。你还记得初学骑自行车时那个不稳定的感觉吗?但随着练习,它变得越来越自然了,甚至可能忘记了那些最初的心惊胆颤。
成功后如何继续努力?
很多人认为一旦成功,就可以松一口气,但实际上这只是旅途中的一个转弯点。在任何一种情况下,都不能停止前进,因为新的机会总是在等待着那些准备好迎接它们的人。不断学习新知识、新技能,可以帮助你适应不断变化的环境,同时也能保证你的位置不会被替代。
最后的思考
最终,无论面对什么样的局面,我们都应该以一种积极主动的心态去看待问题,而不是逃避或抱怨。当别人说给他/her/they一些建议时,他们往往是在指引他们朝着正确方向前进,而不是告诉他们停下来。而当有人问起成功秘诀时,他们通常会回答:“我一直在试错”,因为这正反映了一种不断探索、勇敢尝试,并从错误中学习的心态。这才是真正意义上的“不懈追求”。






